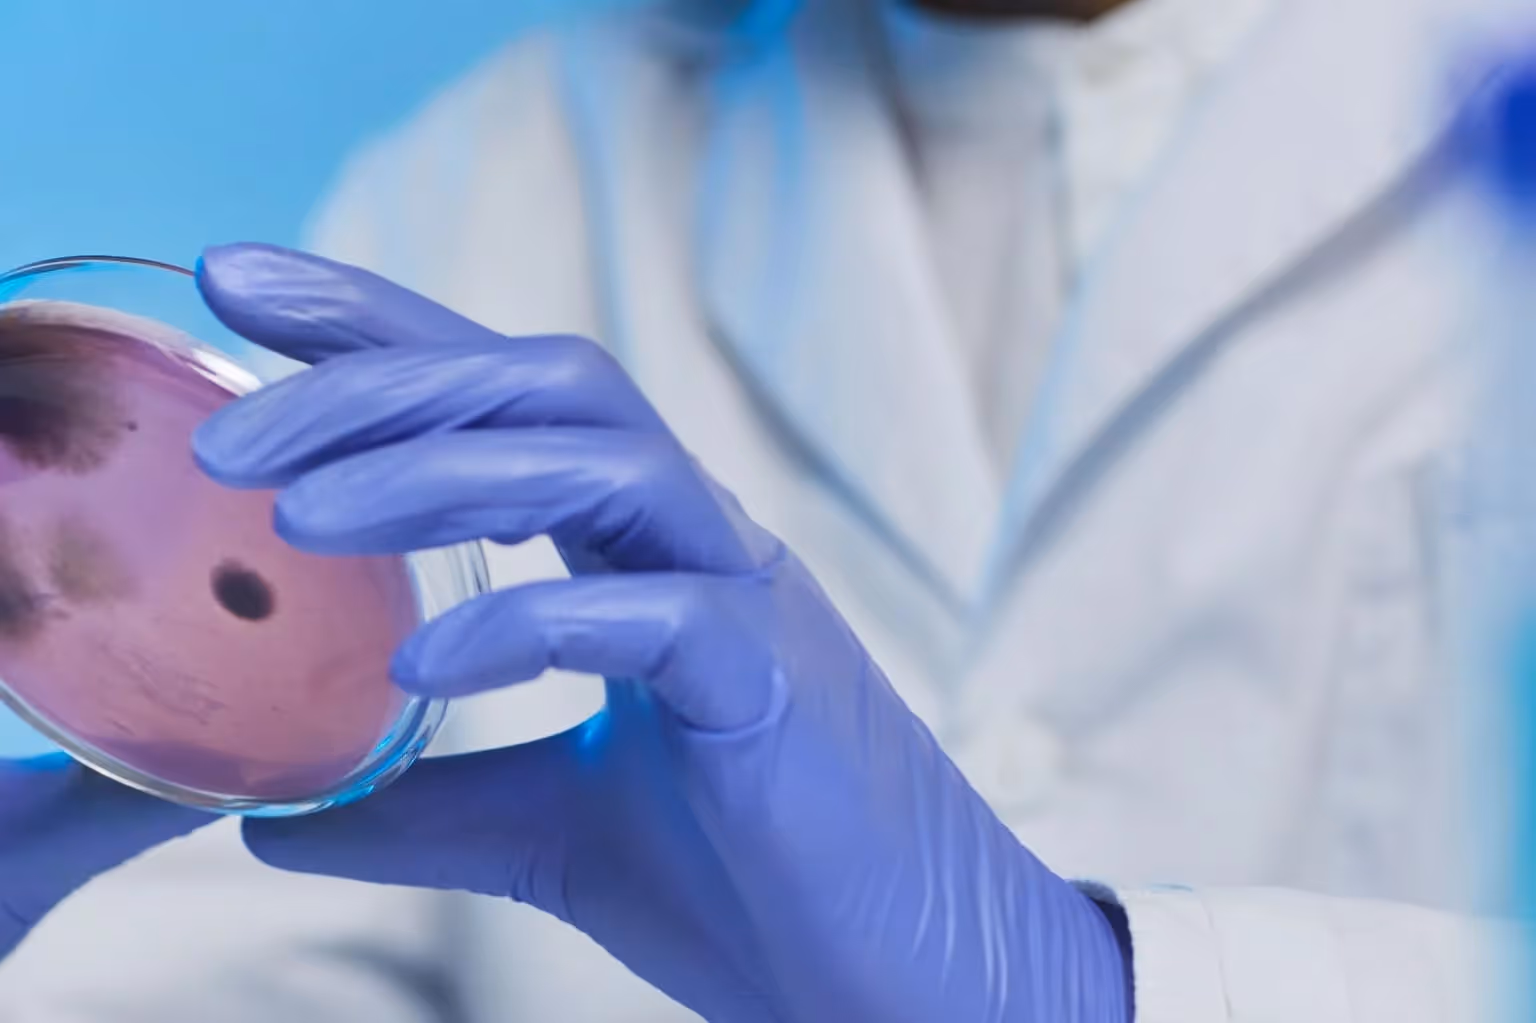

Newborn screening is the process of testing newborns for specific genetic, metabolic, endocrine and other disorders shortly after birth.
Its aim is to catch health issues early on, allowing for quick intervention to prevent serious complications. This early detection improves long-term health outcomes and quality of life for affected infants (Ozben, 2013).

Here are the key reasons and benefits of early disease screening newborns:
Fore Genomics offers enhanced newborn screening by mapping newborns' full genetic profiles using a simple saliva swab to understand their risk for hundreds of diseases. Get started with us today.
Metabolic disorders are a group of conditions that affect how the body processes substances, causing harmful build-ups that impact health.
Some examples of metabolic disorders include:
Hemoglobinopathies like sickle cell disease (SCD) and thalassemia syndromes are inherited blood disorders. They cause issues with the hemoglobin molecule's structure or production.
Endocrine disorders include conditions like congenital hypothyroidism (CH) and congenital adrenal hyperplasia (CAH).
Keeping hormones in balance is crucial for good health, especially during growth. When this balance is disturbed by endocrine disorders, it causes various health issues.
Cystic fibrosis (CF) is a severe genetic disorder that affects the lungs and other organs. This results in respiratory infections, digestive problems, and decreased lung function over time.
NBS for CF typically involves measuring immunoreactive trypsinogen (IRT) from a blood sample taken shortly after birth.
Early detection has been shown to improve nutritional outcomes, growth, and lung function (Dijk & Fitzgerald, 2012).
While CF is the main focus of respiratory disorder screening in newborns, keep in mind that congenital adrenal hyperplasia (CAH) is not a respiratory disorder but an endocrine disorder.
It's included in NBS due to its potential life-threatening consequences if not treated early.
Neurological disorders, such as Spinal Muscular Atrophy (SMA) and various Lysosomal Storage Disorders (LSDs), are also targets for early detection through newborn screening.
Their effect on neurological development is serious.
Parents and healthcare providers need to watch for signs of neurological issues in infants as NBS doesn't catch everything.
Genetic syndromes such as Down Syndrome and Turner Syndrome are chromosomal abnormalities that impact health, development, and quality of life.
Down Syndrome is the most common chromosomal condition diagnosed in the United States, affecting about 1 in every 700 babies (CDC, 2023). It results in intellectual disabilities, distinctive facial features, and heart defects.
Turner Syndrome affects about 1 in 2,500 live female births (Nemours Children’s Health, 2021). It leads to short stature, delayed puberty, infertility, and heart defects. Growth hormone therapy can be started at an appropriate age for children with Turner Syndrome to help improve their development.
Regular health check-ups and monitoring help prevent and manage potential complications associated with these syndromes, such as congenital heart disease.
Spotting sensory issues early lets us start help soon, which can boost kids' language skills, school performance, and social development.
Hearing loss is one of the most common congenital conditions.
Children who undergo early hearing detection and intervention (EHDI) programs achieve better language skills compared to those who are diagnosed later.
While less common than hearing loss in newborns, early detection of vision impairments is just as important. These impairments include congenital cataracts, glaucoma, or retinal disorders.
For hearing loss, interventions include speech therapy, use of sign language, cochlear implants, or other communication devices.
For vision impairments, interventions range from corrective lenses to surgery, accompanied by orientation and mobility training, and other visual rehabilitation services.
Here is a complete list of disorders included in California-based newborn screening, as of October 2020.
You Might Like: How do I Give My Child a Lifetime of Precision Medicine?

1. Hospitals screen newborns by taking a small blood sample from the baby's heel within 48 hours of birth (Genetic Alliance, 2010). At Fore Genomics, we offer a more comprehensive test that checks for many more health conditions using genomics, giving parents and doctors a fuller picture of the baby's health right from the start.
2. This blood is collected on high-grade filter paper, creating what is known as a dried blood spot sample (DBSS). The filter paper preserves the sample's integrity and facilitates its transport to a laboratory.
3. Once the DBSS reaches the laboratory, it undergoes analysis for genetic, metabolic, endocrine and other disorders.
Timing impacts the screening's performance for some metabolic disorders. Samples collected within 24 hours of birth possibly affect the screening results for conditions like phenylketonuria (PKU), isovaleric acidemia (IVA), and methylmalonic acidemia (MMA) (Peng et al., 2021).

When choosing to supplement newborn screening at hospitals with genetic testing from Fore Genomics, consider these points:

When a newborn tests positive for a health condition, the follow-up process begins.
Parenthood comes with the responsibility of ensuring the best start for your newborn. Newborn screening is your ally in this journey, offering a glimpse into your baby's health blueprint.
With services like Fore Genomics, exploring your baby's genetic profile becomes an adventure towards securing a healthier, happier future with the most comprehensive screening available.
Newborn screening is a test performed shortly after birth to detect metabolic, endocrine, genetic and other disorders in newborns. It involves collecting a small blood sample from the baby's heel and analyzing it for health concerns.
Screening newborns for health conditions early can help treat them sooner, avoiding major health problems and helping these babies have a better quality of life. It also provides parents with important information about their baby's health.
Newborn screening happens right after birth to quickly find and start treating health problems early. Children's genetic screening can be done in a preventative health application to detect a child’s predisposition to genetic disease and genetic testing is used to test for specific conditions when there are signs of a problem (e.g. symptoms) or known family history of diseases.